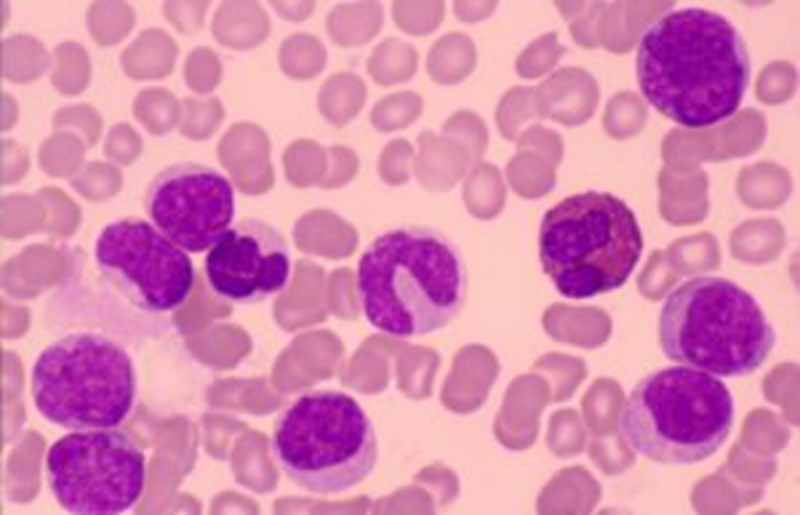

Studies Show Opening Death Gap Among Black Childhood Cancer Patients
A new report found that Black children with cancer have not experienced the same advancements as others of childcare cancer over the past decade.
Today, the leading cause of cancer deaths in children is brain cancer, followed by leukemia. In 2001, mortality rates among Black, Hispanic and white children with cancer were the same. However, data show that the next decade witnessed more of a decline in rates for white children than other groups, according to the Associated Press.
The Cancer in North America discovered the most common types of cancer diagnosed in 2016–2020 among children and adolescents in the United States. These include leukemia, malignant brain and other central nervous system (CNS) tumors, lymphomas, malignant soft tissue sarcomas, malignant germ cell tumors, and malignant bone tumors.
During that time, the incidence rate of leukemia was about twice as high in Hispanic children and adolescents as in Black children and adolescents.
One study, led by Kim D. Miller, MPH, an ACS epidemiologist in the Surveillance and Health Equity Science department, found a 0.7% yearly increase from 2008 to 2017 in incidence rates of cancerous brain tumors among children. Additionally, the five-year survival rates were lowest (70%) in Black children and adolescents with brain cancer and highest (79%) in White patients, as stated in CA: A Cancer Journal for Clinicians.
Why is there an opening death gap? Several years of research and advanced medical therapy and technology have improved survival rates among patients. Despite that, further studies examine the financial burden associated with medical costs among childhood patients and their families.
“You can have the most sophisticated scientific advances, but if we can’t deliver them into every community in the same way, then we have not met our goal as a nation,” said Dr. Sharon Castellino, a pediatric cancer specialist at Emory University’s Winship Cancer Institute in Atlanta, who had no role in the new report.
A research article reported that the median total outpatient hospital cost for “newly diagnosed acute myeloid leukemia patients” was $2,904 per patient, inpatient hospital cost was $83,440 per patient, and ICU cost was $16,550 per patient.
“You need at least one parent to quit their job and be there 24/7, and then figure out the situation for the rest of their children,” Castellino said. “It’s not that families don’t want to do that. It’s difficult.”
St. Jude’s Children’s Research Hospital, for example, does not charge families for treatment, travel, housing, or so they can prioritize their children’s battle for survival. In recent news, St. Jude’s announced its partnership with 10-time Grammy-winning group Take 6. They will be collaborating on the hospital’s “Music Gives to St. Jude‘s Kids” program, designed to connect music lovers their passion for music.
RELATED CONTENT: 34-Year-Old Black Mom Of 5 Dying From Cancer Is Writing A Book For Her Kids
